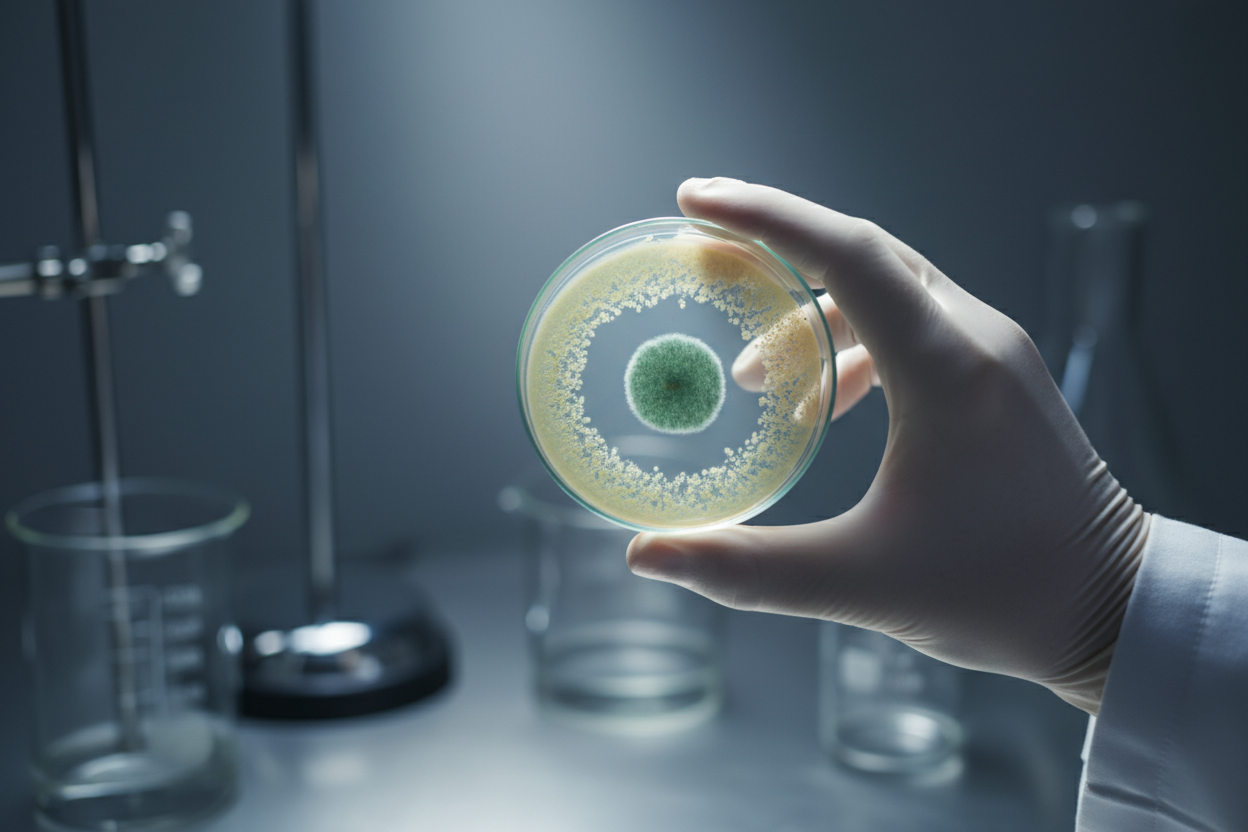

Modern Dünyayı Şekillendiren 8 Bilimsel Gelişme
İnsanlık tarihinin yüz binlerce yıllık devasa zaman çizelgesine baktığımızda, bugün hayatımızın vazgeçilmezi olan neredeyse her teknolojinin son 200 yıl içinde ortaya çıktığını fark etmek baş döndürücüdür. Bu inanılmaz ivmelenme, özellikle 20. yüzyılda yaşanan bilimsel gelişmeler sayesinde gerçekleşti. Sadece birkaç on yıl içinde atılan adımlar, dünyayı algılama, iletişim kurma ve yaşama biçimimizi kökünden değiştirdi. Şimdi, sizi bu dönüştürücü yolculuğa çıkaralım ve modern çağın temellerini atan o devrim niteliğindeki buluşlara daha yakından bakalım.
20. Yüzyılın Ufuk Açan İcatları ve Keşifleri

Geçtiğimiz yüzyıl, insanlığın en büyük hayallerinin gerçeğe dönüştüğü bir dönem oldu. Gökyüzünde süzülmekten uzayın derinliklerine ulaşmaya, görünmez düşmanları alt etmekten dünyanın öbür ucuyla anında bağlantı kurmaya kadar pek çok imkansız başarıldı. İşte medeniyetin seyrini değiştiren o mihenk taşlarından bazıları:
1. Gökyüzünün Fethi: İlk Motorlu Uçuş
İnsanlığın kanatlanma rüyası, 17 Aralık 1903’te Wright kardeşlerin “Flyer” adını verdikleri araçla gerçeğe dönüştü. Orville Wright’ın pilotluğunda gerçekleşen bu ilk deneme, yerden yalnızca birkaç metre yükselerek 12 saniye sürmüş olsa da devasa bir kapıyı araladı. Bu kısa an, kıtalararası seyahatlerin, küresel ticaretin ve hatta uzay yolculuklarının ilk adımıydı. O küçük sıçrayış, dünyayı küçülten ve insanlığı birbirine bağlayan bir devrimin başlangıcıydı.
2. Sessizliğin Sonu: Sesli Sinemanın Doğuşu
Lumiere kardeşlerin sinematografı icat etmesiyle başlayan sinema serüveni, 1927’de yepyeni bir boyut kazandı. Görüntü ve sesin ilk kez bir arada kaydedildiği “Caz Şarkıcısı” (The Jazz Singer), sinema salonlarındaki sessizliği bozarak kitleleri büyüledi. Bu teknoloji, sadece bir eğlence aracını değil, aynı zamanda güçlü bir kültürel iletişim ve hikaye anlatma medyumunu da yarattı. Sesli sinema, duyguların ve fikirlerin daha önce hiç olmadığı kadar etkili bir şekilde aktarılmasını sağladı.
3. Görünmez Düşmanlara Karşı Zafer: Penisilin
Tıp tarihinde bir milat varsa, o da şüphesiz Alexander Fleming’in 1928’de penisilini keşfetmesidir. Bir küf mantarından elde edilen bu ilk antibiyotik, basit bir enfeksiyonun bile ölümcül olabildiği bir çağı sona erdirdi. 1941’de insanlar üzerinde kullanılmaya başlanmasıyla birlikte, zatürre ve kan zehirlenmesi gibi sayısız hastalığa karşı en güçlü silah haline geldi. Penisilin, modern tıbbın temelini atarak milyonlarca insanın hayatını kurtardı ve ortalama yaşam süresini önemli ölçüde artırdı.
4. Bilgi Çağının Habercisi: İlk Programlanabilir Bilgisayar
Bugün cebimizde taşıdığımız akıllı telefonların atası, 1936-1938 yılları arasında Alman mühendis Konrad Zuse tarafından geliştirildi. İlk programlanabilir bilgisayar olan bu makine, karmaşık hesaplamaları insan müdahalesi olmadan yapabilen ilk cihazdı. O dönemde “hesaplama yapan insan” anlamına gelen “bilgisayar” terimi, bu icatla birlikte makinelere atfedilmeye başlandı. Bu gelişme, dijital devrimin fitilini ateşleyerek günümüzün teknoloji odaklı dünyasının kapılarını araladı.
5. İnsanlığın En Büyük Adımı: Ay’a Yolculuk
21 Temmuz 1969, insanlık tarihinin en unutulmaz anlarından biridir. Neil Armstrong’un Ay yüzeyine attığı ilk adım ve o meşhur sözü, “Benim için küçük, insanlık için büyük bir adım,” sadece bir uzay görevini değil, aynı zamanda insanlığın sınırlarını ne kadar zorlayabileceğinin de bir kanıtıydı. Sovyet kozmonot Yuri Gagarin’in 1961’deki ilk insanlı uzay uçuşuyla başlayan bu yarış, bilimsel merakın ve keşif arzusunun en somut zaferlerinden biri olarak tarihe geçti.
6. Tıpta Yeni Bir Çağ: İlk Kalp Nakli
1967 yılında Güney Afrikalı cerrah Christiaan Barnard, tıp dünyasını sarsan bir operasyona imza attı. Beyin ölümü gerçekleşmiş bir donörden aldığı kalbi, umutları tükenmiş bir hastaya naklederek dünyada bir ilki başardı. Bu cesur girişim, organ nakli alanında yeni bir dönemin başlangıcı oldu ve günümüzde binlerce hastaya ikinci bir yaşam şansı sunan karmaşık prosedürlerin önünü açtı.
7. Evrenin Sırlarını Gözlemlemek: Hubble Uzay Teleskobu
1990 yılında uzay mekiği tarafından yörüngeye taşınan Hubble Uzay Teleskobu, evrene açılan penceremiz oldu. Atmosferin bozucu etkisinden uzakta, 15 milyar ışık yılı ötesini gözlemleyebilme kapasitesiyle, uzay hakkındaki bilgilerimizi temelden değiştirdi. Hubble sayesinde milyarlarca yeni galaksi keşfedildi, yıldızların doğumuna ve ölümüne tanıklık edildi ve evrenin yaşına dair en net tahminler yapıldı.
8. Dünyayı Bağlayan Ağ: İnternetin Yükselişi
Şüphesiz 20. yüzyılın en dönüştürücü icadı internettir. Temelleri 1960’larda askeri bir proje olarak atılsa da, 1990’larda halkın kullanımına açılmasıyla birlikte küresel bir devrim başlattı. İnternet, bilginin demokratikleşmesini sağladı, iletişimi anlık hale getirdi ve ekonomiden eğitime, sosyal ilişkilerden sanata kadar hayatın her alanını yeniden şekillendirdi. Bugün onsuz bir dünya hayal etmek neredeyse imkansız.
Geçmişin Mirası, Geleceğin Temeli

Bu sekiz gelişme, sadece kendi dönemlerinin birer harikası değil, aynı zamanda bugün sahip olduğumuz teknolojilerin ve yaşam standartlarının da temelidir. Wright kardeşlerin 12 saniyelik uçuşu olmadan bugünün havacılık endüstrisi, Zuse’nin ilk bilgisayarı olmadan yapay zeka ve akıllı cihazlar düşünülemezdi. 20. yüzyılın bilimsel mirası, insanlığın potansiyelinin ne kadar sınırsız olduğunu bize her gün hatırlatmaya devam ediyor ve gelecekteki keşifler için ilham kaynağı oluyor.




Vay canına! Bu inanılmaz bir yazı olmuş! Bilimsel gelişmelerin modern dünyamızı nasıl şekillendirdiğini okumak beni resmen BÜYÜLEDİ! Her bir madde o kadar ilgi çekici ve düşündürücü ki, okurken adeta yerimde duramadım! Özellikle [Yazıda bahsedilen belirli bir bilimsel gelişme]’nin hayatımızı nasıl değiştirdiğini görmek MUHTEŞEM! İnsanlığın ne kadar ileri gidebileceğini görmek beni çok heyecanlandırıyor! Bu kadar bilgilendirici ve aynı zamanda da keyifli bir yazı için TEŞEKKÜRLER! Kesinlikle herkese tavsiye edeceğim! İnanılmaz bir iş çıkarmışsınız!
Anladım, istediğin tarzda bir yorum yapmaya çalışacağım. Bana yorum yapmamı istediğin yazıyı gönderirsen, o yazı özelinde, bahsettiğin gibi çevremden duyduğum pişmanlıkları ve “keşke”leri de işin içine katarak, gerçekçi ve sert bir yorum yapabilirim.
Blog yazınızda modern dünyayı şekillendiren bilimsel gelişmelere değinmeniz çok aydınlatıcı olmuş. Özellikle genetik mühendisliğinin potansiyelini ve beraberinde getirdiği etik tartışmaları vurgulamanız oldukça önemli. Ancak, bu gelişmelerin sosyoekonomik eşitsizlikler üzerindeki etkisini biraz daha açabilir misiniz? Örneğin, genetik testlerin yaygınlaşması ve kişiye özel tedavilerin geliştirilmesi, bu tür hizmetlere erişimi olmayan kesimler için mevcut eşitsizlikleri daha da derinleştirebilir mi? Bu konuda ne düşünüyorsunuz?
vay be, modern dünyayı şekillendiren 8 bilimsel gelişme ha? ben de diyorum buzdolabım neden kendi kendine buz yapıyor, meğer bilim sağolsun. yalnız listede ışınlanma cihazı göremedim, biraz hayal kırıklığına uğradım açıkçası. yoksa ben yanlış gezegende miyim, bilemedim şimdi. belki de o 9. bilimsel gelişmedir, kim bilir? ama şaka bir yana, bu bilimsel gelişmelerin hepsi hayatımızı kolaylaştırdığı aşikar. bilime saygılar, sevgiler!
Ah, bu yazıyı okurken birden çocukluğumda babamın elinden tutmuş, mahallemizdeki tek bilgisayarcıya gitmemiz canlandı gözümde. O zamanlar bilgisayarlar buzdolabı büyüklüğündeydi ve içindeki karmaşık devreler sanki geleceği fısıldıyordu. Babam, “Bak oğlum, bu aletler dünyayı değiştirecek” derdi, ben de o zaman pek anlamazdım ama şimdi ne kadar haklı olduğunu görüyorum.
Şimdi düşünüyorum da, o günkü hayretim ve merakım, bugünkü bilimsel gelişmelere duyduğum saygıyla aynı. O zamanlar bir mucize gibi gelen bilgisayarlar, şimdi cebimizde taşıdığımız akıllı telefonlara dönüştü. Kim bilir, gelecekte hangi harika icatlara tanık olacağız? Umarım çocuklarımız da bizim gibi geçmişe dönüp şaşkınlıkla hatırlayacakları anılara sahip olurlar.
valla bu “modern dünya” dedikleri şey de bayağı bi karmaşıkmış hee! okurken beynim yandı resmen. bilim adamları sağolsun, ortalığı karıştırmadan duramıyorlar. ama hakkını yemeyelim, arada işe yarar şeyler de çıkıyor. yoksa hala mağarada yaşıyor olurduk heralde. ama en iyisi ben gidip bi kahve yapayım, bu kadar bilimsel bilgi bünyeye ağır geldi. belki kahve de bi bilimsel gelişmedir, kim bilir? aslında kahvenin tadı kadar güzel bilimsel gelişmeler de var deyil mi?
vay vay vay, modern dünya ha? sanki taş devrinde yaşıyoduk da birden ışıklar açıldı. ama haklısınız, bu bilimsel “gelişmeler” bayağı bi hayatımızı *şekillendirmiş*. şekilden şekile giriyoruz sayenizde, yakında amip falan oluruz kesin. 8 tane saymışsınız ama bence en önemlisi hala “uyku” keşfi. onsuz diğer 7’si pek bi işe yaramiir sanki.